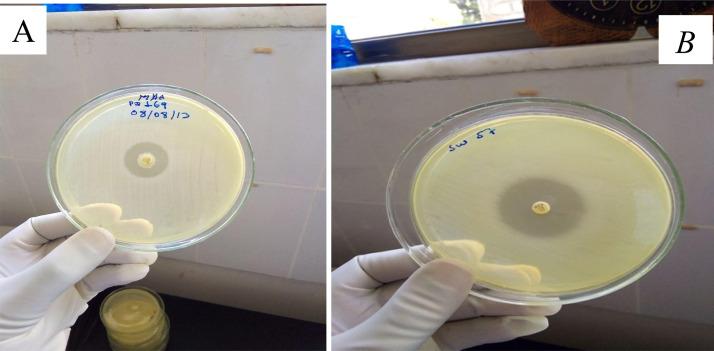

埃塞俄比亚东北部住院患者医院获得性耐碳青霉烯类肠杆菌科细菌感染的流行病学与预防
Epidemiology and prevention of hospital-acquired carbapenem-resistant Enterobacterales infection in hospitalized patients, Northeast Ethiopia.
作者信息
Shibabaw Agumas, Sahle Zenawork, Metaferia Yeshi, Atlaw Asgdew, Adenew Behailu, Gedefie Alemu, Tilahun Mihret, Ebrahim Endris, Kassa Yeshimebet, Debash Habtu, Wang Shu-Hua
机构信息
Department of Medical Laboratory Sciences, College of Medicine and Health Sciences, Wollo University, Dessie, Ethiopia.
Department of Medical Laboratory Sciences, Debre Berhan Health Science College, Debre Berhan, Ethiopia.
出版信息
IJID Reg. 2023 Mar 1;7:77-83. doi: 10.1016/j.ijregi.2023.02.008. eCollection 2023 Jun.
OBJECTIVE
Carbapenemase-producing carbapenem-resistant Enterobacterales (CP-CRE) are usually healthcare associated. The aim of this study was to investigate the epidemiology of hospital-acquired CRE and multi-drug-resistant infections, and identify associated risk factors in hospitalized patients in Northeast Ethiopia.
METHODS
This cross-sectional study was conducted in patients admitted with sepsis between January and June 2021. Demographic and clinical data were collected using questionnaires. In total, 384 samples were collected and cultured based on source of infection. Bacterial species identification was performed using biochemical tests, and drug susceptibility testing was done using the Kirby-Bauer disk diffusion method. The modified carbapenem inactivation method was employed for carbapenemase detection. Data were analysed using Statistical Package for the Social Sciences.
RESULTS
The overall rate of CP-CRE infection was 14.6%. Bloodstream infections and urinary tract infections were the predominant hospital-acquired infections (HAIs). The majority of CP-CRE were and , and accounted for 4.9%. Chronic underlying disease (adjusted odds ratio (AOR): 7.9, 95% confidence interval (CI): 1.9-31.5), number of beds per room (AOR: 11, 95% CI: 1.7-75) and eating raw vegetables (AOR: 11, 95% CI: 3.4-40) were significantly associated with hospital-acquired CRE infection.
CONCLUSIONS
The rate of CP-CRE infection found in this study is concerning. There is a need for further evaluation of risk factors and measures to decrease HAI. Hand hygiene, increased laboratory capacity, improved infection prevention measures, and antimicrobial stewardship programmes are needed in healthcare settings to halt the transmission of CP-CRE.
目的
产碳青霉烯酶的耐碳青霉烯类肠杆菌科细菌(CP-CRE)通常与医疗保健相关。本研究的目的是调查埃塞俄比亚东北部住院患者医院获得性耐碳青霉烯类肠杆菌科细菌(CRE)和多重耐药感染的流行病学,并确定相关危险因素。
方法
本横断面研究于2021年1月至6月对脓毒症住院患者进行。使用问卷收集人口统计学和临床数据。根据感染源共收集384份样本并进行培养。使用生化试验进行细菌种类鉴定,使用 Kirby-Bauer 纸片扩散法进行药敏试验。采用改良碳青霉烯灭活法检测碳青霉烯酶。使用社会科学统计软件包分析数据。
结果
CP-CRE感染的总体发生率为14.6%。血流感染和尿路感染是主要的医院获得性感染(HAIs)。大多数CP-CRE为[具体细菌名称未给出],占4.9%。慢性基础疾病(调整优势比(AOR):7.9,95%置信区间(CI):1.9-31.5)、每间病房床位数(AOR:11,95%CI:1.7-75)和食用生蔬菜(AOR:11,95%CI:3.4-40)与医院获得性CRE感染显著相关。
结论
本研究中发现的CP-CRE感染率令人担忧。需要进一步评估危险因素并采取措施降低医院获得性感染。医疗机构需要加强手卫生、提高实验室能力、改进感染预防措施并实施抗菌药物管理计划,以阻止CP-CRE的传播。